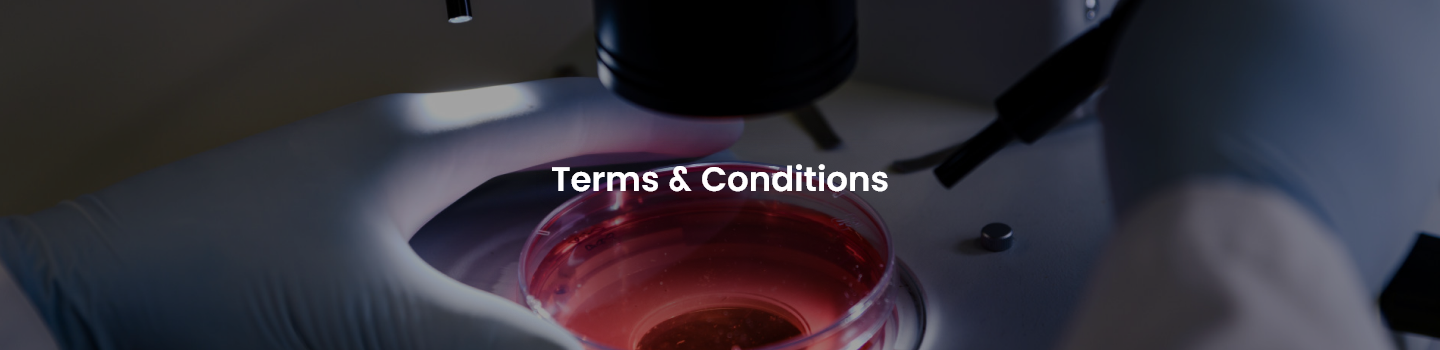
NovaPath Diagnostics Terms and Conditions

These terms of use (this 'Agreement') set forth the standards of use of NOVAPATH DIAGNOSTICS website located at https://novapath-web-uat.abym.us and all of its associated pages and websites. The website and all such associated pages and websites are collectively referred to herein as the 'Website.'
The words 'You' or 'User' 'Your' as used herein refer to all individuals accessing or using the Website for any reason.
By using the Website, You represent that you have read and agree to be bound by the terms of this Agreement, as well as any other guidelines, privacy policy, rules and additional terms referenced herein, collectively referred to as 'Terms of Use'. These Terms of Use set out the legally binding terms with respect to your access and use of the Website and our provision of the Services (as defined below).
Please read these Terms of Use carefully. Your access to Website and/or use of the Service constitutes your acceptance of all the provisions of these Terms of Use. If you are unwilling to be bound by these Terms of Use, do not access Website and/or use the Service.
1. DEFINITIONS AND INTERPRETATIONS
1.1 Definitions
'Account' means the account successfully opened by the User on the Company's Website by inserting information such as name, age, sex, contact details, user name, password as required to be filled in the webpage during the registration process and includes any further changes and additions to the information from time to time.
'Company' means NOVAPATH DIAGNOSTICS Pvt. Ltd or any of its assignee, incorporated under the applicable laws.
'Customer' means any User who accesses the Website and completes the registration according to clause 6.
'Histopathology & Cytology Services' means the specialized diagnostic services including tissue analysis, cytology examinations, and other pathology services being offered by the Company and any such other services which the Company may introduce from time to time through web portal.
'Fee' means the price prescribed by the Company for the Services as notified on its Website from time to time.
'Home/Clinic Collection Service' means the facility provided by the Company to facilitate sample collection at the Customer's preferred location.
'Order ID' means the unique identification identity allotted to a Customer upon placing a request for booking the Services.
'Registration Process' means the entire process which a Customer/User undergoes while registering himself on the Website in accordance with clause 6.
'Services' means the services as mentioned in clause 3.2.
'User' means any person who accesses the Website.
1.2 Interpretation
In this Agreement, unless the context otherwise requires references to recitals, clauses and sub-clauses are to recitals, clauses and sub-clauses of this Agreement; headings are inserted for ease of reference only and are not to be used to define, interpret or limit any of the provisions of this Agreement; references to the singular number shall include references to the plural number and vice versa; words denoting one gender include all genders; any reference in this Agreement to a statutory provision includes that provision and any regulation made in pursuance thereof, as from time to time modified or re-enacted, whether before or after the date of this Agreement; and any reference to a time limit in this Agreement means the time limit set out in the relevant clause or sub-clause or such other time limit which may be mutually agreed by the parties in writing.
2. ELIGIBILITY
2.1 You, if an individual, must be 18 or above, or the legal age to form a binding contract in your jurisdiction if that age is greater than 18 years of age, to use the Website and Services. Use of this Website is void where prohibited by applicable law, and the right to access the Website will be deemed to be revoked in such jurisdictions ab initio. By using the Website and/or the Services, You represent and warrant that You have the right, authority, and capacity to enter into these Terms of Use and to abide by all of the terms and conditions set forth herein. You also represent and warrant to the Company that You will use Website in a manner consistent with any and all applicable laws and regulations.
3. SERVICES
3.1 Use of this Website entitles the User, whether a User or a Customer, to avail certain services as provided in the following clauses ('Services') and interpretation of the term 'Services' shall be done accordingly depending upon the context.
3.2 The Users are entitled to the following Services:
3.2.1 If You have not completed the registration as per clause 6, You are entitled to view information about various diagnostic services and offers being offered on the Website.
3.2.2 If You have completed the registration as per clause 6, on the payment of Fee, You are entitled:
a) to view information about various diagnostic services and offers being offered on the Website;
b) to book one or more diagnostic services;
c) to opt for Home/Clinic Collection Service (if available at that period of time) wherein the Company shall send its representatives to your preferred location for the sample collection or You may visit the nearest collection center of the Company to give the sample. However, You shall have to visit the designated test centers/laboratories if the Company requires You to do so;
d) to receive email/SMS/phone calls/letters which shall provide You with the Order ID, the service details and other relevant information;
e) to receive the diagnostic reports within the suggested time.
f) By using the 'Get Call Now' feature, I agree to be contacted by NOVAPATH DIAGNOSTICS.
3.3 The Services are non-transferable i.e. only the person on whose name the service is assigned at the time of booking will be eligible to avail the Services at the lab or through home/clinic collection.
3.4 In case a booking is made before 4 pm on a business day, the Company shall endeavour to give a confirmation to the Customer on the same day and if it is received after 4 pm, the Company shall endeavour to give a confirmation to the Customer the next business day.
3.5 The Customer is required to carry a photo-identification card, a copy of the invoice and Order ID or the transaction number at the time of visit to the Lab or when availing Home/Clinic Collection Service.
3.6 You are advised to go through the list of instructions/guidelines that is provided by the Company on its Website detailing the preparation requirements before providing samples for various tests.
3.7 The Company may put further terms and conditions with every service and in case of any conflict with the Terms of Use or Privacy Policy, the terms and conditions put specifically with the service shall prevail.
3.8 The Company reserves the right to change the nature of Services as mentioned in clause 3.2 at its sole discretion. Such change may be notified to the User/Customer by publishing the same on the Website.
4. RESTRICTIONS ON USE
4.1 You shall not use the Website in order to transmit, distribute, store or destroy material, including without limitation content provided by the Company:
a) for any unlawful purpose or in violation of any applicable law, regulation, international law or laws of any other country; or
b) in a manner that will infringe the copyright, trademark, trade secret or other intellectual property rights of others or violate the privacy, publicity or other personal rights of others, or
c) that is defamatory, libelous, obscene, threatening, abusive or is offensive to users of the Website, such as content or messages that promotes racism, bigotry, hatred or physical harm of any kind against any group or individual; or
d) that is false or misleading; or
e) that harasses or advocates harassment of another person.
4.2 You are also prohibited from violating or attempting to violate the security of the Website, including, without limitation the following activities:
(a) accessing data not intended for You or logging into a server or account which You are not authorized to access;
(b) attempting to probe, scan or test the vulnerability of a system or network or to breach security or authentication measures without proper authorization;
(c) attempting to interfere with service to any user, host or network, including, without limitation, via means of submitting a virus to Website, overloading, 'flooding', 'spamming', 'mail bombing', 'hacking' or 'crashing'; or
(d) forging any TCP/IP packet header or any part of the header information in any e-mail or newsgroup posting. Violations of system or network security may result in civil or criminal liability.
4.3 Specific Restrictions on Rights to Use: In addition to the above, You shall not:
a) modify, adapt, translate, or reverse engineer any portion of the Website and/or Services;
b) remove any copyright, trademark or other proprietary rights notices contained in or on the Website and/or Service;
c) use any robot, spider, site search/retrieval application, or other device to retrieve or index any portion of the Website and/or Service or for crawling the Website and scraping content or to circumvent the technological methods adopted by the Website to prevent such prohibited use;
d) reformat or frame any portion of the web pages that are part of the Website and/or Service;
e) create user accounts by automated means or under false or fraudulent pretenses;
f) create or transmit unwanted electronic communications such as 'spam' to other users/customers of the Website and/or Service or otherwise interfere with other User's or Customer's enjoyment of the Website and/or Service;
g) submit any content or material that falsely express or imply that such content or material is sponsored or endorsed by the Company or the Website;
h) transmit any viruses, worms, defects, Trojan horses or other items of a destructive nature;
i) make use of the Website or Services to violate the security of any computer network, crack passwords or security encryption codes, transfer or store illegal material including that are deemed threatening or obscene;
j) copy or store any content offered on the Website for other than Your own use;
k) take any action that imposes, or may impose in our sole discretion, an unreasonable or disproportionately large load on the Company's IT infrastructure.
5. REMEDIES WITH THE COMPANY
5.1 You understand and agree that the Company or the Website may review any content and in case the Company finds, in its sole discretion, that the User violates any terms of this Agreement especially clause 4, the Company and/or the Website reserves the right to take actions to prevent/control such violation including without limitation, removing the offending communication or content from the Website and/or terminating the membership of such violators and/or blocking their use of the Website and/or Service.
5.2 The Company shall also be entitled to investigate occurrences which may involve such violations and may take appropriate legal action, involve and cooperate with law enforcement authorities in prosecuting Users/Customers who are involved in such violations.
6. REGISTRATION PROCESS
6.1 The User to be entitled to avail the Services shall have to complete the registration process ('Registration Process') as provided below:
a) The Registration Process involves the creating of a login id by the User.
b) Registration is mandatory for the Customers and requires them to provide certain basic information about themselves such as name, age, sex, email address, billing address, collection address, zip/postal code and phone number and accordingly create an Account.
6.2 After completing the Registration Process, the Users become Customers and become entitled to avail the Services as mentioned in the Clause 3.2, subject to payment of the Fee.
6.3 The Website may provide the facility to keep certain information confidential except the information which are considered mandatory by the Company. The Company further reserved the right to seek further information, even if not provided by You, if in its sole view such information is necessary.
6.4 The Customers understand and agree that the Company may screen and verify the information provided by the Customer/User and at its sole discretion, increase the amount or number of information for the Registration Process and may ask for further information even after Registration Process. The Company may in its sole discretion, close the Account, if any information provided is found to be false or the information provided is not sufficient.
7. PAYMENT
7.1 The Company shall endeavour to provide the Customer with facilities/gateways to pay the Fee through credit cards, debit cards, and other online payment methods.
7.2 It is understood and agreed by the User/Customer that the Services shall only commence after realization of money in the accounts of the Company in case online payment is being opted for by them.
7.3 It is understood and agreed by the User/Customer that payment mechanisms may be governed by separate/additional terms of use prescribed by the Company.
7.4 The Company reserves the right to refuse or cancel any order placed for a service that is listed at an incorrect price. This shall be regardless of whether the order has been confirmed and/or payment been levied via credit card. In the event the payment has been processed by the Company, the same shall be credited to your account within 7-14 working days and duly notified to you by email. Once the order has been placed and in case You wish to cancel/modify the same You may do so subject to cancellation/modification charges as prescribed.
7.5 It is understood and agreed by the User/Customer that payment mechanisms may be governed by separate agreements between the third parties who provide facilities for such payment mechanism and the Company.
7.6 It is understood and agreed by the User/Customer that in no event whatsoever, the Company shall take any responsibility or liability for malfunctioning or defect in any payment procedure. Payment of the Price shall be the sole responsibility of the User/Customer.
7.7 The Company reserves the right to charge listing fees for certain listings, as well as transaction fees based on certain completed transactions using the Services through the Website or any other fee. The Company further reserves the right to alter any and all fees from time to time, without notice.
7.8 The User/Customer may be liable to pay all applicable charges, fees, duties, taxes, levies and assessments for availing the Services through the Website. Further, the Company reserves the right to change the Fees upon its sole discretion without any prior notice to the Customers/Users.
8. REFUND AND CANCELLATION POLICY
8.1 The service is valid for a specified period from the time and date of invoice generation. After this period, the Customer shall not be entitled to claim for Services and the company shall have the right to forfeit the fees already paid in such a case.
8.2 Cancellation shall be acceptable only if the Customer informs the Company within a specified time from the time of booking. The Customer can contact us through our official email id in case of cancellation and refund.
8.3 The refund amount will be sent to the respective debit card/credit card/account from where payment was made and amount will not be refundable by any other mode.
9. DELIVERY OF REPORTS
9.1 The Company shall endeavour to release the diagnostic report/s to the Customer within the specified time frame, unless it is required otherwise. Please allow the minimum time required for processing as specified for the test. Time taken during transit/shipping in case it is delivered by courier is extra to the processing time displayed on the site.
9.2 The Customer/s may also collect the reports by hand during working hours from the designated collection center/branch of the Company.
9.3 The diagnostic reports may also be displayed on the Website within the prescribed period and You may track the same by entering your Order ID.
10. MODIFICATION OF TERMS OF USE
10.1 You understand and agree that these Terms of Use, the Website and the Services can be modified by the Company at its sole discretion, at any time without prior notice, and such modifications will be effective upon such new terms and/or upon implementation of the new changes on the Website. You agree to review the Terms of Use periodically so that you are aware of any such modifications and the Company shall not be liable for any loss suffered by You on your failure to review such modified Terms of Use. Unless expressly stated otherwise, any new features, new services, enhancements or modifications to the Website or Service implemented after your initial access of Website or use of the Service shall be subject to these Terms of Use.
11. MAINTENANCE
11.1 The Company may at its sole discretion and without assigning any reason whatsoever at any time deactivate or/and suspend the User's/Customer's access to the Website and/or the Services (as the case may be) without giving any prior notice, to carry out system maintenance or/and upgrading or/and testing or/and repairs or/and other related work. Without prejudice to any other provisions of this Agreement, the Company shall not be liable to indemnify the User for any loss or/and damage or/and costs or/and expense that the User may suffer or incur, and no fees or/and charges payable by the User to the Company shall be deducted or refunded or rebated, as a result of such deactivation or/and suspension.
12. TERM AND TERMINATION
12.1 These Terms of Use, with modifications as contemplated, shall remain in full force and effect during the user of the Website for all Users.
12.2 For Customers, the Terms of Use shall commence from the time the Registration Process is concluded as per clause 6 of this Agreement and shall be valid until terminated as provided below or till the time the Account is maintained.
12.3 The Company may terminate this Agreement with immediate effect, without prior notice and without assigning any reason/s whatsoever and without any prejudice to any/all other rights in the following events:
a) where the Account remains unused for a period of six months or more; or
b) if in the opinion of the Company, the User has breached any of the terms and conditions of this Agreement or/and the Terms of Use; or
c) if, in the opinion of the Company or/and any regulatory authority, it is not in the public interest to continue providing the use or Service to the User for any reason.
12.4 Notwithstanding anything contained in the Terms of Use, clauses related to liabilities, intellectual property, confidentiality, and dispute resolution shall survive any termination or expiration of these Terms of Use.
13. LIABILITIES UPON TERMINATION
13.1 If the Terms of Use is terminated pursuant to clauses set out in clause 12 above, without prejudice to any other remedies available to the Company, You shall not be refunded whether a part or whole of the Fee.
14. OWNERSHIP
14.1 Any material, content or logos, marks, software on or part of the Website and all aspects thereof, including all copyrights and other intellectual property or proprietary rights therein, is owned by the Company or its licensors. You acknowledge that the Website and any underlying technology or software on the Website or used in connection with rendering the Services are proprietary information owned or duly licensed to the Company, except where it is indicated otherwise. You are prohibited to modify, reproduce, distribute, create derivative works of, publicly display or in any way exploit, any of the content, software, marks, logos, and/or materials available on the Website in whole or in part except as expressly allowed under the Terms of Use. You have no other express or implied rights to use, in any manner whatsoever, the content, software, marks, logos, and/or materials available on the Website.
15. COPYRIGHT DISPUTE POLICY
15.1 The Company has adopted the following general policy towards copyright infringement:
15.2 If the Company believes in good faith any material on its Website has been illegally copied or is posted, uploaded or made accessible through the Website or Services and distributed by any advertisers, its affiliates, content providers, members or Users; it shall send an Infringement Notice and remove and discontinue Services to offenders.
15.3 If despite the Infringement Notice, the offender does not take the requisite steps, the Company shall have the right to proceed against the offender by filing a suit in the appropriate court of law on ground of such infringement.
16. DISCLAIMER
16.1 THE WEBSITE IS PROVIDED BY THE COMPANY ON AN 'AS IS' BASIS THE COMPANY AND ITS LICENSORS AND AFFILIATES MAKE NO REPRESENTATIONS OR WARRANTIES OF ANY KIND, EXPRESS, STATUTORY OR IMPLIED AS TO THE OPERATION OF THE WEBSITE, PROVISION OF SERVICES OR SOFTWARE OR THE INFORMATION, CONTENT, MATERIALS, OR PRODUCTS INCLUDED ON THE WEBSITE OR IN ASSOCIATION WITH THE SERVICES. TO THE FULLEST EXTENT PERMISSIBLE BY APPLICABLE LAW, THE COMPANY AND ITS LICENSORS AND AFFILIATES DISCLAIM ALL WARRANTIES, EXPRESS, STATUTORY, OR IMPLIED, INCLUDING, BUT NOT LIMITED TO, IMPLIED WARRANTIES OF MERCHANTABILITY AND FITNESS FOR A PARTICULAR PURPOSE AND NON-INFRINGEMENT.
16.2 ALL THE CONTENTS OF THIS WEBSITE ARE ONLY FOR GENERAL INFORMATION OR USE. THEY DO NOT CONSTITUTE ANY MEDICAL ADVICE AND SHOULD NOT BE RELIED UPON IN MAKING (OR REFRAINING FROM MAKING) ANY DECISION. AS PROFESSIONAL CLINICAL LABORATORY SCIENTISTS, OUR GOAL IS TO ASSIST YOU IN UNDERSTANDING THE PURPOSE OF LABORATORY TESTS AND THE GENERAL MEANING OF YOUR LABORATORY RESULTS. IT IS IMPORTANT THAT YOU COMMUNICATE WITH YOUR PHYSICIAN SO THAT TOGETHER YOU CAN INTEGRATE THE PERTINENT INFORMATION, SUCH AS AGE, ETHNICITY, HEALTH HISTORY, SIGNS AND SYMPTOMS, LABORATORY AND OTHER PROCEDURES, TO DETERMINE YOUR HEALTH STATUS. THE INFORMATION PROVIDED THROUGH THIS SERVICE IS NOT INTENDED TO SUBSTITUTE FOR SUCH CONSULTATIONS WITH YOUR PHYSICIAN NOR MEDICAL ADVICE SPECIFIC TO YOUR HEALTH CONDITION.
16.3 SINCE THE COMPANY ACTS ONLY AS A SERVICE PORTAL FOR THE USERS/CUSTOMERS, IT SHALL NOT HAVE ANY LIABILITY WHATSOEVER FOR ANY ASPECT OF THE PAYMENT BETWEEN THE THIRD PARTY AND THE CUSTOMER/USER.
16.4 IN NO EVENT SHALL THE COMPANY BE LIABLE FOR ANY DIRECT, INDIRECT, PUNITIVE, INCIDENTAL, SPECIAL, CONSEQUENTIAL DAMAGES OR ANY OTHER DAMAGES RESULTING FROM: (A) THE USE OR THE INABILITY TO USE THE SERVICES; (B) UNAUTHORIZED ACCESS TO OR ALTERATION OF THE USER'S TRANSMISSIONS OR DATA; (C) ANY OTHER MATTER RELATING TO THE SERVICES; INCLUDING, WITHOUT LIMITATION, DAMAGES FOR ANY LOSS WHATSOEVER ARISING OUT OF OR IN ANY WAY CONNECTED WITH THE USE OR PERFORMANCE OF THE WEBSITE.
17. LIMITATION ON LIABILITY
17.1 The Company shall not be liable for any failure to perform its obligations hereunder where such failure results from any cause beyond the Company's reasonable control, including, without limitation, mechanical, electronic or communications failure or degradation. WITHOUT LIMITING THE FOREGOING, THE COMPANY AND ITS AFFILIATES AND SUPPLIERS WILL NOT BE LIABLE UNDER ANY LAW, FOR ANY INDIRECT, INCIDENTAL, PUNITIVE, AND CONSEQUENTIAL DAMAGES, INCLUDING, BUT NOT LIMITED TO LOSS OF PROFITS, SERVICE INTERRUPTION, AND/OR LOSS OF INFORMATION OR DATA.
18. INDEMNITY
18.1 You agree to indemnify and hold the Company, its parents, subsidiaries, affiliates, officers and employees, harmless, including costs and attorneys' fees, from any claim or demand made by any third party due to or arising out of (i) your access to the Website, (ii) your use of the Services, (iii) the violation of these Terms of Use by You, or (iv) the infringement by You, or any third party using Your account or User ID or password, of any intellectual property or other right of any person or entity.
19. PRIVACY
19.1 Use of the Website and/or the Services is also governed by our Privacy Policy.
20. CONFIDENTIALITY
20.1 For the purpose of this Agreement and attachments thereto and all renewals, 'Confidential Information' means all information (including any information relating to the Account, username or password etc.), methods developed for analysis, examination and verification and other such details (the 'Disclosing Party') or, which may be supplied to or may otherwise come into the possession of the other (the 'Receiving Party'), whether orally or in writing or in any other form, and which is confidential or proprietary in nature or otherwise expressed by the Disclosing Party to be confidential and is not generally available to the public.
20.2 The Receiving Party shall keep confidential and secret and not disclose to any third party the Confidential Information or any part of it. The Receiving Party agrees to take all possible precautions with regard to protecting Confidential Information from any third party.
20.3 Further no use, reproduction, transformation or storage of the Confidential Information shall be made by the User without the prior written permission of the Company, except where required to be disclosed pursuant to any applicable law or legal process issued by any court or the rules of any competent regulatory body.
20.4 All information and data submitted by the User shall become the property of the Company and all such information shall be disclosed in accordance with the Terms of Use.
20.5 The User has access to only his own data and information stored in the database at Website (subject to prior confirmation of identity) and nothing more. The User may edit or amend such data and information from time to time, if Company provides such an option.
21. MISCELLANEOUS
21.1 Governing law and Dispute Resolution - This Agreement and Terms of Use shall be governed by and constructed in accordance with the laws of India only without reference to conflict of laws principles and all disputes arising in relation hereto shall be subject to the exclusive jurisdiction of the courts of [City, State], India.
21.2 Assignability - The Company may assign any of its responsibilities/obligations to any other Person without notice to the User, at its sole discretion. However, You shall not assign, sub-licence or otherwise transfer any of your rights under these Terms of Use to any other party, unless a written consent is taken from the Company.
21.3 Severability - If any provision of these Terms of Use is found to be invalid, the invalidity of that provision will not affect the validity of the remaining provisions of the Terms of Use, which shall remain in full force and effect.
21.4 Waiver - Failure by the Company to exercise any right or remedy under these Terms of Use does not constitute a waiver of that right or remedy.
21.5 Force Majeure - The Company is not liable for failure to perform any of its obligations if such failure is as a result of Acts of God (including fire, flood, earthquake, storm, hurricane or other natural disaster), war, invasion, act of foreign enemies, hostilities (regardless of whether war is declared), civil war, rebellion, revolution, insurrection, military or usurped power or confiscation, terrorist activities, nationalisation, government sanction, blockage, embargo, labor dispute, strike, or any interruption or any failure of electricity or server, system, computer, internet or telephone service.
21.6 Grievance Redressal: The Company shall endeavour to address grievance or complaints of the Users to the extent possible. Towards this the user can contact the Grievance Officer of the Company at [email address].
21.7 Links to third party sites
a) The Website may contain links to other websites ('Linked Sites'). The Linked Sites are not under the control of the Company or the Website and the Company is not responsible for the contents of any Linked Site, including without limitation any link contained in a Linked Site, or any changes or updates to a Linked Site. The Company is not responsible for any form of transmission, whatsoever, received by the User from any Linked Site. The Company is providing these links to the User only as a convenience, and the inclusion of any link does not imply endorsement by the Company or the Website of the Linked Sites or any association with its operators or owners including the legal heirs or assigns thereof.
b) The Company is not responsible for any errors, omissions or representations on any Linked Site. The Company does not endorse any advertiser on any Linked Site in any manner. The Users are requested to verify the accuracy of all information on their own before undertaking any reliance on such information.
22. COMMUNICATION
When you visit the Website or use it to send emails/SMS, provide information or communicate to us, You understand and agree that you are communicating with us through electronic records. You hereby provide your consent to receive communications via electronic records from us periodically or as and when required. Further, you allow us to communicate with you through email or by such other mode of communication, electronic or otherwise as the need may be.
23. SOCIAL MEDIA TERMS
By participating in the social media contests, polls, engagement activities, etc. that would be posted on social media or shared through email, SMS, or WhatsApp, participants acknowledge that they have read, understood, and agreed to abide by these terms and conditions.
The above-mentioned activities are only engagement activities of NOVAPATH DIAGNOSTICS. Participation in any contest is voluntary. Please read the terms and conditions carefully.
Participants must be human individuals and may not be automated bots or machines.
You shall be legally competent to enter into a binding contract under the applicable laws of India.
All who fulfil the eligibility criteria to participate in the Contest shall individually be considered and referred to as "Participant" and collectively "Participants" for the purpose of these T&Cs.
In case of any dispute, Delhi courts will have exclusive jurisdiction.
NOVAPATH DIAGNOSTICS reserves the right to cancel or amend the competition and these terms and conditions without notice.
The competition and these terms and conditions will be governed by Indian law and any disputes will be subject to the exclusive jurisdiction of the courts of Delhi.
These 'Terms & Conditions' and 'Privacy Policy' of the Website constitute a binding agreement between You and the Company, and is accepted by You upon your use of the Website.